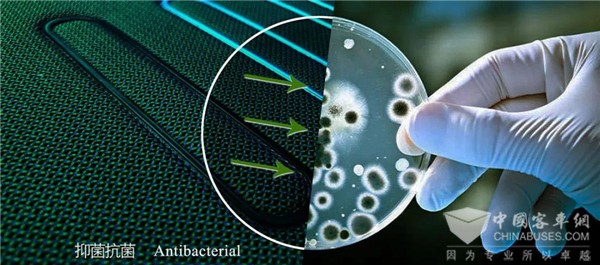

全面防控 出行无忧 金龙“全健康客车”正式上市!

疫情的肆虐牵动着全国人民的心,短短数天时间全国皆被疫情点亮,防控工作迫在眉睫!时值春运出行高峰期,公共交通出行的安全防控成了客车行业的重中之重!
金龙客车作为以谋求大众交通安全、舒适、环保与便捷为使命,为大众交通而生的客车行业骨干企业,早在2003年抗击“非典”时期,便推出“健康客车”系列车型, 通过加装专利产品——TDK车载空气电子除菌清新器,对车内空气进行快速度、高强度、无死角杀菌消毒,消毒时无须停车或乘客下车,且对人体无毒无害无污染,大大改善了车内空气质量、保障了乘客出行的健康安全。
《商用汽车》2003年第五期
17年后,面对来势汹汹的新型冠状病毒肺炎,金龙客车再一次发起了实力冲锋!在公司党委坚强有力的领导下,金龙客车全体干部职工众志成城,为打赢疫情防控阻击战全力冲锋,让金龙的“可信赖文化”在抗疫战斗中熠熠生辉!
金龙客车从春节开始就组织精兵强将,加班加点全力研发升级“健康客车”,正式推出“全健康客车”!以全功能健康、全流程健康的全面防控,打造真正意义上的全方位健康智慧客车,保障公众的出行卫生安全,减轻客运企业疫情防控工作的压力。


“全方位健康安全客车”针对公共交通工具人员密度大、流动性强和空间密闭的特点进行研发设计,是在原有专利技术TDK车载空气电子除菌技术的基础上,针对新型冠状病毒的传播特点,在病毒防范技术上的再次升级。全功能健康与全流程健康相结合,实现真正意义上的全方位健康安全保障!
全功能健康
金龙全健康客车通过配备多项关键性设施和多种智能化系统,可实现“健康呼吸”“健康接触”“健康检测”“健康防护”四种强大功能,达到全功能健康。

1、健康呼吸
金龙全健康客车通过多级空气过滤+多种除菌消毒措施,如在顶厢灯上增加紫外线消毒灯,安装空气净化天窗,利用紫外线照射空调风道内的空气和光触媒网等,对车厢环境起到消毒杀菌作用,确保车内空气清洁安全,使乘客和驾驶员实现健康呼吸。


2、健康接触
通过将具有长效抗菌功能的原材料应用到车内可接触物(如座椅、窗帘、地板等)中,金龙全健康客车能够有效提升乘客区的抗菌抑菌等级,降低交叉感染的几率。
3、健康检测
客车搭载人体体温监测系统,利用热成像技术,快速检查发热人群;搭载乘客电子画像流动数据防控系统,通过人像识别、大数据分析等技术,为敏感人群筛查和追踪提供高效手段,为防范疫情传播提供可靠保障。

4、健康防护
全健康客车搭载公共客舱消毒喷淋系统,通过固定喷头对车内全方位无死角自动喷淋,高效完成车内乘客易接触物(扶手/座椅/地面等)及空气的消毒灭菌,具有高度集中、智能控制的特点,能够满足公共交通快速运营的需求,有效助力疫情防控,保障广大乘客的出行安全。


同时金龙全健康客车可在车辆后部设置具备独立换气系统的负压应急隔离舱,有效隔离疑似人群,避免交叉感染。

全流程健康
金龙全健康客车通过金龙龙翼车联网平台能够实现智能的远程控制,从动态监测、实时追踪、在线防毒杀菌到应急隔离、集中消杀的全流程把关,从而有效地灭杀病毒,防范疫情的进一步扩散。
全健康客车实现联防联控
金龙客车推出的“全健康客车”,不仅能够保障大众的出行安全,还能为敏感人群的筛查和跟踪提供有效渠道;而且通过智能远程控制,集中消杀病毒,智能生成报表上报,让一线公共交通的防疫状态及时有效纳入监控体系,实现全面的联防联控。

此时,金龙客车工厂机器轰鸣,疫情突击组正加班加点赶制“全方位健康安全客车”。2020年2月18日金龙客车全面复工,为奋战在客运一线的客户,全力以赴提供健康客车和售后保障服务!
营运车辆升级无忧
针对现有的营运车辆,金龙客车还推出“全健康升级包”,健康包通过“健康呼吸”功能和公共客舱消毒喷淋系统,有效杀灭车厢接触物和空气中的细菌和病毒。每辆在路上行驶的金龙客车都能选择加装整套健康包,保障广大民众的出行安全。
不仅如此,针对防疫救治一线的特殊用车需求,金龙客车在春节期间紧急赶制负压救护车,此刻也正竭尽全力研制正压医疗指挥车、隔离病人转运车、无人消毒车和隔离舱等产品,切实为抗击病毒,打赢防治新型冠状病毒的攻坚战提供有力保障!
1、凡本网注明“来源:www.beltsegypt.com” 的所有作品,版权均属于完美作业网有免费视频,未经本网授权,任何单位及个人不得转载、摘编或以其它方式使用上述作品。已经本网授权使用作品的,应在授权范围内使用,并注明“来源:www.beltsegypt.com”。违反上述声明者,本网将追究其相关法律责任。
2、凡本网注明 “来源:XXX(非完美作业网有免费视频)” 的作品,均转载自其它媒体,转载目的在于传递更多信息,并不代表本网赞同其观点和对其真实性负责。
3、如因作品内容、版权和其它问题需要同本网联系的,请在30日内进行。
※ 有关作品版权事宜请联系:copyright#chinabuses.com
- 国庆假期收官,藕粉出行体验分享来啦![10-08]
- 合肥国际新能源车展 安凯引领“智·电”出行[10-01]
- 智驭未来 匠心筑梦 中车电动第五届职业技能大赛冠军揭晓[09-30]
- 打卡《黑神话:悟空》取景地 还得靠依维柯4X4[09-30]
- 中通H11交付首汽 助建首都高质量旅游客运服务体系[09-29]
- 绿色公交“新风景”安凯纯电动G6批量上岗绍兴 [09-29]
- 公共出行焦虑重重 欧辉客车BJ6859帮你做好情绪管理[09-29]
- 梦想1+1 VIP 中通客车助力森煜汽运打造彩云之南高端旅游靓丽名片[09-29]